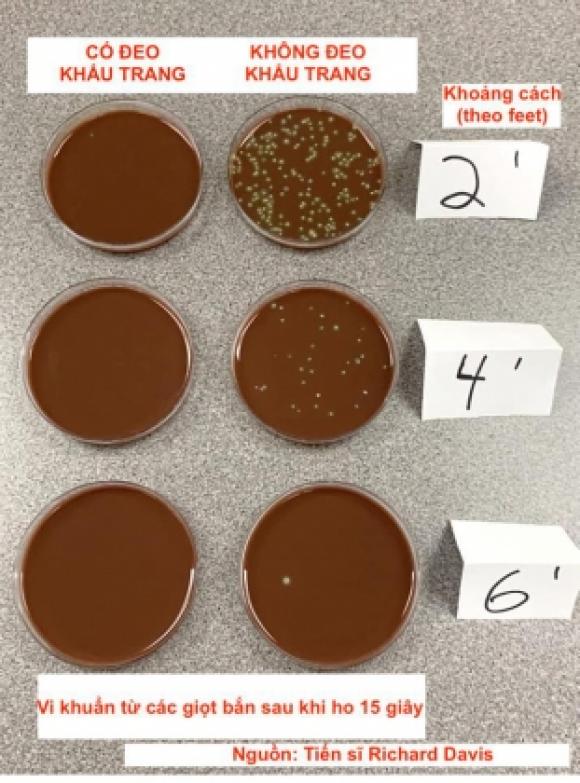
42 3 Tien Si My Lam Thi Nghiem Ve Hieu Qua Cua Khau Trang  La Chan Covid 19 Khien Ai Cung Kinh Ngac

Tiến sĩ Rich Davis, giám đốc phòng thí nghiệm vi sinh lâm sàng tại trung tâm y tế Providence Sacred Heart, thành phố Spokane, bang Washington đã chứng minh hiệu quả ngăn chặn hầu hết các giọt bắn trong lúc chúng ta hô hấp – phương tiện mà các nhà nghiên cứu tin rằng đã làm phát tán virus nCoV trong cộng đồng.

Trên tài khoản Twitter của mình, tiến sĩ Davis đã đăng tải quá trình thực hiện, kết quả thu được và kết luận sau các thí nghiệm của mình. Ở thí nghiệm thứ nhất, anh đặt môi trường thạch (dùng để nuôi cấy vi khuẩn) gần mặt để xem có bao nhiêu giọt bắn ra trong lúc anh nói chuyện, hát, hắt hơi và ho, xét trong trường hợp anh có và không đeo khẩu trang.
Kết quả cho thấy, khi Davis không đeo khẩu trang, với chỉ một cái hắt hơi, các giọt bắn đã lấp đầy môi trường thạch cùng những tập đoàn vi khuẩn hình thành trong phương tiện này. Hành động ho, hát và nói chuyện cũng cho kết quả tương tự, vi khuẩn đã theo các giọt bắn hô hấp xuất hiện trên môi trường thạch.
Trong khi đó, khi Davis đeo khẩu trang và thực hiện những hành động trên thì các môi trường thạch được khảo sát hầu như “sạch sẽ”!

Kết quả thí nghiệm thứ nhất của Tiến sĩ Davis
Trong thí nghiệm thứ hai, tiến sĩ Davis đã xem xét đến yếu tố khoảng cách, vì giãn cách xã hội cũng là một cách phổ biến khác để phòng chống virus nCoV lây lan trong cộng đồng.
Anh đặt đĩa môi trường nuôi cấy vi khuẩn cách hai, bốn và sáu feet (tương đương khoảng hơn 60, 121 và 182 cm) và ho mạnh trong khoảng 15 giây, xét trong trường hợp đeo và không đeo khẩu trang. Kết quả nhận được là trong khi hầu hết các giọt bắn đã rơi xuống các đĩa môi trường trong phạm vi dưới 6 feet (khoảng hơn 182 cm) thì với trường hợp anh đeo khẩu trang thì hầu như tất cả các giọt bắn này đã bị chặn lại, bất kể ở khoảng cách nào!
Kết quả thí nghiệm thứ hai của Tiến sĩ D
Đương nhiên, tiến sĩ Davis có lưu ý rằng hai thí nghiệm trên không tương đồng với sự lây lan của virus nCoV gây dịch COVID-19. “Vi khuẩn rất khác biệt với virus! Nhưng vì chúng tôi tin rằng các giọt bắn khi hô hấp là phương tiện chủ yếu lây lan dịch COVID19, tôi khai thác sự hiện diện của vi khuẩn (dễ dàng phát triển và hình dung) trong các giọt hô hấp, để cho thấy chúng phát tán đi đâu”, ông giải thích.
Giáo sư virus học tại Đại học Seattle Pacific, Tiến sĩ, Bác sĩ Tracie Delgado đã lý giải và làm rõ thêm một số câu hỏi từ thí nghiệm của tiến sĩ Davis:
Thí nghiệm này trên vi khuẩn vậy còn với virus thì sao?
– Virus khó phát hiện hơn vi khuẩn vì phải làm nhiều bước thí nghiệm hơn và cần thiết bị tiên tiến hơn. Ngoài ra, hầu hết mọi người không có virus trong cơ thể nên người làm thí nghiệm (tiến sĩ Davis) sẽ cần tìm người nhiễm virus. Tuy nhiên, một nghiên cứu được thử nghiệm rộng rãi được công bố cho thấy khẩu trang ngăn chặn virus lây lan với tất cả các bước và thiết bị bổ sung.

– Lý do tiến sĩ Davis sử dụng vi khuẩn trong thí nghiệm này là để đưa ra một sự thể hiện trực quan dễ tiếp cận rằng mặt nạ có thể ngăn ngừa mầm bệnh nói chung. Mặt nạ có thể chặn hầu hết các giọt bắn ra khỏi miệng cùng mầm bệnh trong nó (dù là vi khuẩn hay virus). Đó chính là cách khẩu trang giúp làm chậm sự gia tăng số ca nhiễm COVID-19 mới. Đúng là virus nhỏ hơn vi khuẩn nhưng hãy nhớ virus lây lan qua những giọt bắn nhỏ khi ta hô hấp. Vì vậy, nếu khẩu trang ngăn được hầu hết các giọt dịch bị người bệnh bắn ra thì khẩu trang cũng chặn được hầu hết các loại virus truyền nhiễm.
Khẩu trang vải có giúp bảo vệ chúng ta tốt như khẩu trang y tế không?
– Khẩu trang vải chặn khoảng 50% kích thước giọt bắn thoát khỏi người bị nhiễm bệnh và khẩu trang y tế ngăn khoảng 75% kích thước giọt bắn từ bệnh nhân. Nhưng nhìn chung cả hai đều khá tương đồng trong việc ngăn chặn tỷ lệ lây nhiễm từ người bị nhiễm sang người không nhiễm bệnh. Lượng virus đóng vai trò lớn trong việc bạn có bị nhiễm bệnh hay không. Cả khẩu trang vải và khẩu trang y tế đều làm giảm số lượng virus phát tán (bằng cách hứng các giọt bắn chứa virus).

– Hãy nhớ rằng, mặt nạ không bảo vệ bạn, chúng bảo vệ người khác khỏi nguy cơ nhiễm bệnh từ bạn (nếu bạn mắc bệnh).
Nguồn: SOHA


Ý kiến bạn đọc